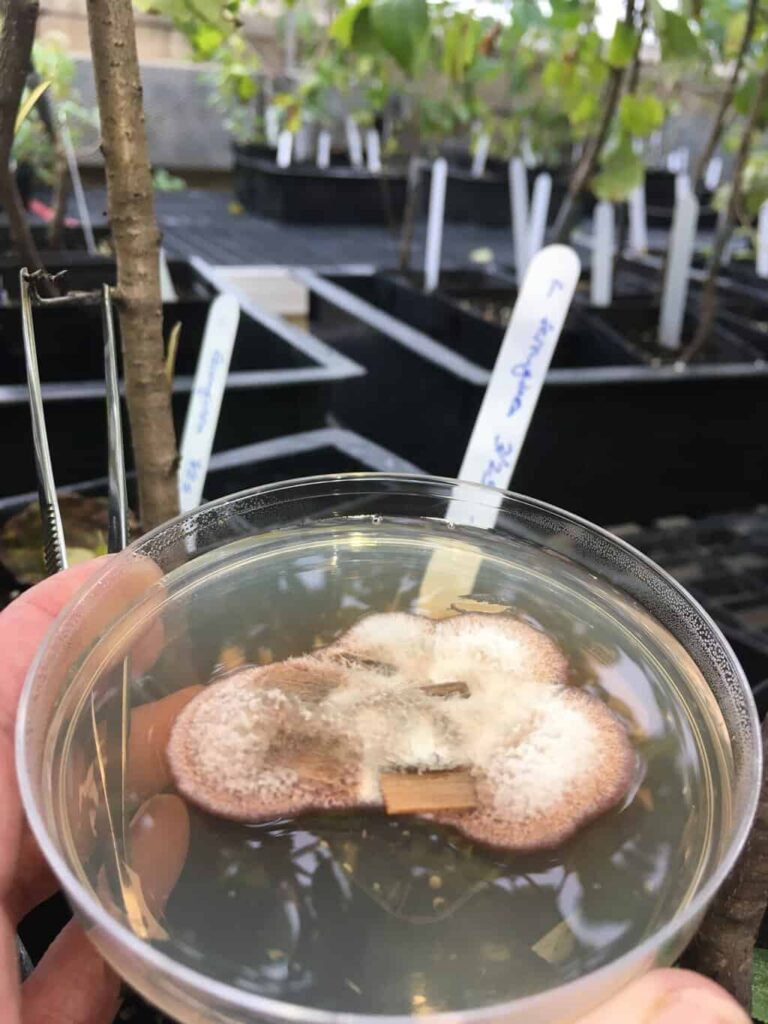
Close-up of a petri dish containing a fuzzy fungal culture, held up in front of rows of labeled potted buckthorn saplings in a greenhouse.

By Ryan Franke, 2024 MMS Graduate Scholarship Winner
From brewing beer to producing antibiotics, modern society relies on fungal life processes to fulfill our desires and overcome our obstacles. How about the buckthorn problem? Can fungi help us get rid of invasive buckthorn? This is the central question of my research in the UMN Forest Pathology lab under the direction of Professor Robert (Bob) Blanchette.
Developing a Mycoherbacide
Our approach to developing a mycoherbicide for buckthorn can be summarized in three steps:
- Collect fungi from dead and dying buckthorn and other diseased hardwoods.
- Test this collection of fungi for their ability to cause disease in healthy buckthorn.
- Develop a methodology for application of the fungi to buckthorn in the field that can be used by land managers.
Last summer, fellow researchers in the Blanchette lab and I answered the call to visit fifteen sites across Minnesota and Wisconsin with dead and dying buckthorn. We were tipped off to a handful of these locations by citizen scientists. Minnesota and Wisconsin state personnel brought many more to our attention. Dieback from the top of the stem toward the base of the trunk to varying degrees was the most frequently observed symptom across all sites.
We also found localized cankers originating at branch stubs at some of the sites. A canker is an area of dead inner bark walled off from healthy tissue by thick, reactionary callus tissue. Back in the lab, we excised small pieces of diseased tissue and placed them onto agar media. Then we and waited for the resident fungi to emerge and spread across the petri dish. We extracted the DNA of each fungal isolate and sequenced the ITS “barcode” region of DNA. This can be used to identify most fungi to a particular species.
Sidenote: Biological Nomenclature
If you’re a little fuzzy on biological nomenclature, here’s a familiar example to help you gain some traction for the next piece of information. Morchella esculenta, the prized edible delicacy, belongs to the genus Morchella. It is more narrowly defined by its species name, esculenta. Presently, we have identified 294 isolates (individual fungi) as 89 unique species belonging to 64 genera (plural of genus). It’s fascinating to know that so many different fungi are associated with dead and dying buckthorn.
Now, the task at hand is to separate the chaff (decomposers, weak pathogens, endophytes) from the wheat (fungi capable of ruining vigorously growing buckthorn). First, we needed to determine whether a species in our collection may be pathogenic to buckthorn. Then, we looked for evidence in the scientific literature of serious pathogenicity on woody plants. This review helped us narrow down the list of potential candidates for biocontrol from 89 to 29 species.
Transplanting Buckthorn for Research
During an unseasonably warm day last October, I uprooted 300 buckthorn saplings from their cozy residence on the UMN campus. Then, I transplanted them into our greenhouse. Despite being leafed out, every single tree survived transplanting. What a tenacious plant!
Since then, I’ve been using the saplings to screen our likely candidate fungi from dead and dying buckthorn for their ability to cause disease in healthy buckthorn. To do this, I grow the fungi on birch wood chips. Once mycelium has covered the wood chips, I make a wound in the sapling and insert the wood chip into the wound. After introducing the inoculum, I wrap the wound site with parafilm wax paper. This keeps the fungus from drying out, and secondly wrap with duct tape to eliminate potential harm to the fungus by UV radiation. After 3 months, I will harvest the saplings and measure the size of the canker surrounding the wound. This will serve as my metric for pathogenicity.
A Track Record of Success with Mycoherbicides
In addition to fungi isolated from dead and dying buckthorn, I’ve included several generalist fungal pathogens isolated from non-buckthorn hosts in the greenhouse inoculation study. One of these pathogens, Chondrostereum purpureum has been licensed as the active ingredient in a few different commercial mycoherbicide products in Canada over the past 20 years. These products have been used to prevent the resprouting of hardwood stumps, including invasive buckthorn. In fact, this fungus has been particularly well studied as a mycoherbicide. Research shows no significant effects on the environment beyond its targets.
Although we are pleased to be testing multiple Chondrostereum purpureum isolates that we have collected locally, this fungus is just one of 50 species that we are in the process of testing. This summer, we will begin experimenting with various inoculum formulations as applied to cut buckthorn stumps. So, can fungi help us get rid of buckthorn? I’d say the odds are pretty good.

About Ryan Franke

Ryan Franke grew up in Eagan, MN and learned to revere the natural world at a young age. During a fall camping trip around Lake Superior in 2015, he became fascinated with fungi and shortly thereafter joined the Minnesota Mycological Society. His fascination with fungi mushroomed after joining the society. He opened a gourmet mushroom cultivation business in 2017. Ryan was editor of the MMS newsletter from 2018-2020. More recently, he joined the mycology-focused Forest Pathology Lab at the UMN in 2023.